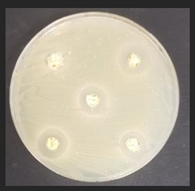
Plants 11 03080 i003

Combined Thermomechanical–Biological Treatment for Corn By-Product Valorization into Added-Value Food (Feed) Material
Abstract
1. Introduction
2. Materials and Methods
2.1. Corn By-Products and Technological Microorganisms Used in Experiments
2.2. Analysis of the Acidity Parameters and Microbiological Characteristics
2.3. Analysis of the Amino Acids Profile and Biogenic Amines Concentration
2.4. Determination of Sugars Concentration in Corn By-Product Samples
2.5. Evaluation of Fatty Acids Profile
2.6. Evaluation of Antimicrobial Properties
2.7. Statistical Analysis
3. Results and Discussion
3.1. Acidity Parameters and Microbiological Characteristics of the Corn By-Products
3.2. Amino Acids Profile and Biogenic Amines Formation in Corn By-Products
3.3. Sugars Concentration in Corn By-Product Samples
3.4. Corn By-Products Fatty Acids Profile
3.5. Antimicrobial Characteristics of Corn By-Products
4. Conclusions
Supplementary Materials
Author Contributions
Funding
Institutional Review Board Statement
Informed Consent Statement
Data Availability Statement
Acknowledgments
Conflicts of Interest
References
- Luithui, Y.; Baghya Nisha, R.; Meera, M.S. Cereal By-Products as an Important Functional Ingredient: Effect of Processing. J. Food Sci. Technol. 2019, 56, 1–11. [Google Scholar] [CrossRef]
- Tsadik, Y.Y.G.; Emire, S.A. Development of Value Added Products from Byproducts of Ethiopian Wheat Milling Industries. J. Food Process. Technol. 2015, 6, 1. [Google Scholar]
- Staller, J. Maize Cobs and Cultures: History of Zea mays L.; Springer Science & Business Media: Berlin/Heidelberg, Germany, 2009; ISBN 3-642-04506-5. [Google Scholar]
- Scott, M.P.; Emery, M. Maize: Overview. Encyclopedia of Food Grains, 2nd ed.; Faubion, J., Ed.; Elsevier: Amsterdam, The Netherlands, 2015; ISBN 9780123944375. [Google Scholar]
- Wang, L.; Liu, H.-M.; Xie, A.-J.; Zhu, C.-Y.; Qin, G.-Y. Dietary Fiber Extraction from Defatted Corn Hull by Hot-Compressed Water. Pol. J. Food Nutr. Sci. 2018, 68, 133–140. [Google Scholar] [CrossRef]
- Ranum, P.; Peña-Rosas, J.P.; Garcia-Casal, M.N. Global Maize Production, Utilization, and Consumption. Ann. N. Y. Acad. Sci. 2014, 1312, 105–112. [Google Scholar] [CrossRef] [PubMed]
- Ai, Y.; Jane, J. Macronutrients in Corn and Human Nutrition. Compr. Rev. Food Sci. Food Saf. 2016, 15, 581–598. [Google Scholar] [CrossRef]
- Ostrander, B.M. Maize Starch for Industrial Applications. In Industrial Crops; Springer: Berlin/Heidelberg, Germany, 2015; pp. 171–189. [Google Scholar]
- Decimo, M.; Quattrini, M.; Ricci, G.; Fortina, M.G.; Brasca, M.; Silvetti, T.; Manini, F.; Erba, D.; Criscuoli, F.; Casiraghi, M.C. Evaluation of Microbial Consortia and Chemical Changes in Spontaneous Maize Bran Fermentation. AMB Express 2017, 7, 205. [Google Scholar] [CrossRef]
- Zhang, R.; Ma, S.; Li, L.; Zhang, M.; Tian, S.; Wang, D.; Liu, K.; Liu, H.; Zhu, W.; Wang, X. Comprehensive Utilization of Corn Starch Processing By-Products: A Review. Grain Oil Sci. Technol. 2021, 4, 89–107. [Google Scholar] [CrossRef]
- Dey, D.; Richter, J.K.; Ek, P.; Gu, B.-J.; Ganjyal, G.M. Utilization of Food Processing By-Products in Extrusion Processing: A Review. Front. Sustain. Food Syst. 2021, 4, 603751. [Google Scholar] [CrossRef]
- Zhang, Y.; He, Z.; Xu, M.; Zhang, X.; Cao, S.; Hu, Y.; Luan, G. Physicochemical Properties and Protein Structure of Extruded Corn Gluten Meal: Implication of Temperature. Food Chem. 2022, 399, 133985. [Google Scholar] [CrossRef]
- Saleh, A.S.; Zhang, Q.; Chen, J.; Shen, Q. Millet Grains: Nutritional Quality, Processing, and Potential Health Benefits. Compr. Rev. Food Sci. Food Saf. 2013, 12, 281–295. [Google Scholar] [CrossRef]
- Gulati, P.; Brahma, S.; Rose, D. Impacts of Extrusion Processing on Nutritional Components in Cereals and Legumes: Carbohydrates, Proteins, Lipids, Vitamins, and Minerals. In Extrusion Cooking; Woodhead Publishing: Amsterdam, The Netherlands, 2020; pp. 415–436. ISBN 978-0-12-815360-4. [Google Scholar]
- Bartkiene, E.; Lele, V.; Ruzauskas, M.; Domig, K.J.; Starkute, V.; Zavistanaviciute, P.; Bartkevics, V.; Pugajeva, I.; Klupsaite, D.; Juodeikiene, G.; et al. Lactic Acid Bacteria Isolation from Spontaneous Sourdough and Their Characterization Including Antimicrobial and Antifungal Properties Evaluation. Microorganisms 2020, 8, 64. [Google Scholar] [CrossRef]
- Bartkiene, E.; Bartkevics, V.; Krungleviciute, V.; Pugajeva, I.; Zadeike, D.; Juodeikiene, G. Lactic Acid Bacteria Combinations for Wheat Sourdough Preparation and Their Influence on Wheat Bread Quality and Acrylamide Formation. J. Food Sci. 2017, 82, 2371–2378. [Google Scholar] [CrossRef] [PubMed]
- Cai, H.-L.; Zhu, R.-H.; Li, H.-D. Determination of Dansylated Monoamine and Amino Acid Neurotransmitters and Their Metabolites in Human Plasma by Liquid Chromatography–Electrospray Ionization Tandem Mass Spectrometry. Anal. Biochem. 2010, 396, 103–111. [Google Scholar] [CrossRef] [PubMed]
- Ben-Gigirey, B.; Vieites Baptista de Sousa, J.M.; Villa, T.G.; Barros-Velazquez, J. Histamine and Cadaverine Production by Bacteria Isolated from Fresh and Frozen Albacore (Thunnus alalunga). J. Food Prot. 1999, 62, 933–939. [Google Scholar] [CrossRef] [PubMed]
- Bartkiene, E.; Gruzauskas, R.; Ruzauskas, M.; Zokaityte, E.; Starkute, V.; Klupsaite, D.; Vadopalas, L.; Badaras, S.; Özogul, F. Changes in the Microbial Community and Biogenic Amine Content in Rapeseed Meal during Fermentation with an Antimicrobial Combination of Lactic Acid Bacteria Strains. Fermentation 2022, 8, 136. [Google Scholar] [CrossRef]
- Cizeikiene, D.; Juodeikiene, G.; Paskevicius, A.; Bartkiene, E. Antimicrobial Activity of Lactic Acid Bacteria against Pathogenic and Spoilage Microorganism Isolated from Food and Their Control in Wheat Bread. Food Control 2013, 31, 539–545. [Google Scholar] [CrossRef]
- Evans, J.D. Straightforward Statistics for the Behavioral Sciences; Thomson Brooks/Cole Publishing Co.: Belmont, CA, USA, 1996; ISBN 0-534-23100-4. [Google Scholar]
- Nnam, N.M.; Obiakor, P.N. Effect of Fermentation on the Nutrient and Antinutrient Composition of Baobab (Adansonia Digitata) Seeds and Rice (Oryza Sativa) Grains. Ecol. Food Nutr. 2003, 42, 265–277. [Google Scholar] [CrossRef]
- Nkhata, S.G.; Ayua, E.; Kamau, E.H.; Shingiro, J.-B. Fermentation and Germination Improve Nutritional Value of Cereals and Legumes through Activation of Endogenous Enzymes. Food Sci. Nutr. 2018, 6, 2446–2458. [Google Scholar] [CrossRef]
- Garrido-Galand, S.; Asensio-Grau, A.; Calvo-Lerma, J.; Heredia, A.; Andrés, A. The Potential of Fermentation on Nutritional and Technological Improvement of Cereal and Legume Flours: A Review. Food Res. Int. 2021, 145, 110398. [Google Scholar] [CrossRef]
- Wang, Z.; Yan, J.; Ma, S.; Tian, X.; Sun, B.; Huang, J.; Li, L.; Wang, X.; Bao, Q. Effect of Wheat Bran Dietary Fiber on Structural Properties of Wheat Starch after Synergistic Fermentation of Lactobacillus Plantarum and Saccharomyces Cerevisiae. Int. J. Biol. Macromol. 2021, 190, 86–92. [Google Scholar] [CrossRef]
- Trakselyte-Rupsiene, K.; Juodeikiene, G.; Alzbergaite, G.; Zadeike, D.; Bartkiene, E.; Ozogul, F.; Rueller, L.; Robert, J.; Rocha, J.M.F. Bio-Refinery of Plant Drinks Press Cake Permeate Using Ultrafiltration and Lactobacillus Fermentation into Antimicrobials and Its Effect on the Growth of Wheatgrass in Vivo. Food Biosci. 2022, 46, 101427. [Google Scholar] [CrossRef]
- Adebo, O.; Njobeh, P.; Adeboye, A.; Adebo, J.; Sobowale, S.; Ogundele, O.M.; Kayitesi, E. Advances in Fermentation Technology for Novel Food Products. In Innovations in Technologies for Fermented Food and Beverage Industries; Springer: Cham, Switzerland, 2018; pp. 71–87. ISBN 978-3-319-74819-1. [Google Scholar]
- Adebo, O.A.; Njobeh, P.B.; Kayitesi, E. Fermentation by Lactobacillus Fermentum Strains (Singly and in Combination) Enhances the Properties of Ting from Two Whole Grain Sorghum Types. J. Cereal Sci. 2018, 82, 49–56. [Google Scholar] [CrossRef]
- Gunasekaran, Y.K.; Lele, V.; Sakiene, V.; Zavistanaviciute, P.; Zokaityte, E.; Klupsaite, D.; Bartkevics, V.; Guiné, R.P.; Bartkiene, E. Plant-based Proteinaceous Snacks: Effect of Fermentation and Ultrasonication on End-product Characteristics. Food Sci. Nutr. 2020, 8, 4746–4756. [Google Scholar] [CrossRef]
- Kim, C.; Ndegwa, E. Influence of PH and Temperature on Growth Characteristics of Leading Foodborne Pathogens in a Laboratory Medium and Select Food Beverages. Austin Food Sci. 2018, 1, 1031. [Google Scholar]
- Ayyash, M.; Johnson, S.K.; Liu, S.-Q.; Mesmari, N.; Dahmani, S.; Al Dhaheri, A.S.; Kizhakkayil, J. In Vitro Investigation of Bioactivities of Solid-State Fermented Lupin, Quinoa and Wheat Using Lactobacillus spp. Food Chem. 2019, 275, 50–58. [Google Scholar] [CrossRef] [PubMed]
- Ferrero, F.; Piano, S.; Tabacco, E.; Borreani, G. Effects of Conservation Period and Lactobacillus Hilgardii Inoculum on the Fermentation Profile and Aerobic Stability of Whole Corn and Sorghum Silages. J. Sci. Food Agric. 2019, 99, 2530–2540. [Google Scholar] [CrossRef]
- Pontonio, E.; Dingeo, C.; Gobbetti, M.; Rizzello, C.G. Maize Milling By-Products: From Food Wastes to Functional Ingredients Through Lactic Acid Bacteria Fermentation. Front. Microbiol. 2019, 10, 561. [Google Scholar] [CrossRef]
- Onyango, C.; Noetzold, H.; Bley, T.; Henle, T. Proximate Composition and Digestibility of Fermented and Extruded Uji from Maize–Finger Millet Blend. LWT-Food Sci. Technol. 2004, 37, 827–832. [Google Scholar] [CrossRef]
- Zhang, J.; Liu, M.; Zhao, Y.; Zhu, Y.; Bai, J.; Fan, S.; Zhu, L.; Song, C.; Xiao, X. Recent Developments in Fermented Cereals on Nutritional Constituents and Potential Health Benefits. Foods 2022, 11, 2243. [Google Scholar] [CrossRef]
- Zhao, H.-M.; Guo, X.-N.; Zhu, K.-X. Impact of Solid State Fermentation on Nutritional, Physical and Flavor Properties of Wheat Bran. Food Chem. 2017, 217, 28–36. [Google Scholar] [CrossRef]
- Xiao, Z.; Wang, K.; Li, F.; Cao, H.; Duan, Q.; Zhu, M.; Wang, P.; Gao, Y.; Duan, Y. Effect of Extrusion on Physical and Chemical Properties and Storage Stability of Corn Germ. Cereal Chem. 2021, 98, 1135–1145. [Google Scholar] [CrossRef]
- Kholodilina, T.N.; Atlanderova, K.N.; Kurilkina, M.Y. Effect of the Extrusion Process on the Amino Acid Components Profile of the Broilers Diet. IOP Conf. Ser. Earth Environ. Sci. 2021, 848, 012056. [Google Scholar] [CrossRef]
- Chaiyakul, S.; Jangchud, K.; Jangchud, A.; Wuttijumnong, P.; Winger, R. Effect of Extrusion Conditions on Physical and Chemical Properties of High Protein Glutinous Rice-Based Snack. LWT Food Sci. Technol. 2009, 42, 781–787. [Google Scholar] [CrossRef]
- Singh, S.; Gamlath, S.; Wakeling, L. Nutritional Aspects of Food Extrusion: A Review. Int. J. Food Sci. Technol. 2007, 42, 916–929. [Google Scholar] [CrossRef]
- Rodriguez, D.A.; Lee, S.A.; Jones, C.K.; Htoo, J.K.; Stein, H.H. Digestibility of Amino Acids, Fiber, and Energy by Growing Pigs, and Concentrations of Digestible and Metabolizable Energy in Yellow Dent Corn, Hard Red Winter Wheat, and Sorghum May Be Influenced by Extrusion. Anim. Feed Sci. Technol. 2020, 268, 114602. [Google Scholar] [CrossRef]
- Alvarez, M.A.; Moreno-Arribas, M.V. The Problem of Biogenic Amines in Fermented Foods and the Use of Potential Biogenic Amine-Degrading Microorganisms as a Solution. Trends Food Sci. Technol. 2014, 39, 146–155. [Google Scholar] [CrossRef]
- Kongkiattikajorn, J. Potential of Starter Culture to Reduce Biogenic Amines Accumulation in Som-Fug, a Thai Traditional Fermented Fish Sausage. J. Ethn. Foods 2015, 2, 186–194. [Google Scholar] [CrossRef]
- Bandeira, C.M.; Evangelista, W.P.; Gloria, M.B.A. Bioactive Amines in Fresh, Canned and Dried Sweet Corn, Embryo and Endosperm and Germinated Corn. Food Chem. 2012, 131, 1355–1359. [Google Scholar] [CrossRef]
- Montet, D.; Ray, R.C. Fermented Foods, Part I: Biochemistry and Biotechnology; Taylor & Francis Group: Abingdon, UK, 2020; ISBN 978-0-367-73745-0. [Google Scholar]
- Muñoz-Esparza, N.C.; Latorre-Moratalla, M.L.; Comas-Basté, O.; Toro-Funes, N.; Veciana-Nogués, M.T.; Vidal-Carou, M.C. Polyamines in Food. Front. Nutr. 2019, 6, 108. [Google Scholar] [CrossRef]
- Izquierdo-Pulido, M.; Mariné-Font, A.; Vidal-Carou, M.C. Biogenic Amines Formation during Malting and Brewing. J. Food Sci. 1994, 59, 1104–1107. [Google Scholar] [CrossRef]
- Bartkiene, E.; Zokaityte, E.; Lele, V.; Sakiene, V.; Zavistanaviciute, P.; Klupsaite, D.; Bendoraitiene, J.; Navikaite-Snipaitiene, V.; Ruzauskas, M. Technology and Characterisation of Whole Hemp Seed Beverages Prepared from Ultrasonicated and Fermented Whole Seed Paste. Int. J. Food Sci. Technol. 2020, 55, 406–419. [Google Scholar] [CrossRef]
- Mao, M.; Wang, P.; Shi, K.; Lu, Z.; Bie, X.; Zhao, H.; Zhang, C.; Lv, F. Effect of Solid State Fermentation by Enterococcus Faecalis M2 on Antioxidant and Nutritional Properties of Wheat Bran. J. Cereal Sci. 2020, 94, 102997. [Google Scholar] [CrossRef]
- Matthews, A.; Grbin, P.R.; Jiranek, V. A Survey of Lactic Acid Bacteria for Enzymes of Interest to Oenology. Aust. J. Grape Wine Res. 2006, 12, 235–244. [Google Scholar] [CrossRef]
- Aktas-Akyildiz, E.; Masatcioglu, M.T.; Köksel, H. Effect of Extrusion Treatment on Enzymatic Hydrolysis of Wheat Bran. J. Cereal Sci. 2020, 93, 102941. [Google Scholar] [CrossRef]
- Sanjeev, P.; Chaudhary, D.P.; Sreevastava, P.; Saha, S.; Rajenderan, A.; Sekhar, J.C.; Chikkappa, G.K. Comparison of Fatty Acid Profile of Specialty Maize to Normal Maize. J. Am. Oil Chem. Soc. 2014, 91, 1001–1005. [Google Scholar] [CrossRef]
- Wu, S.; Peng, Y.; Xi, J.; Zhao, Q.; Xu, D.; Jin, Z.; Xu, X. Effect of Sourdough Fermented with Corn Oil and Lactic Acid Bacteria on Bread Flavor. LWT 2022, 155, 112935. [Google Scholar] [CrossRef]
- Chen, J.; Liu, H. Nutritional Indices for Assessing Fatty Acids: A Mini-Review. Int. J. Mol. Sci. 2020, 21, 5695. [Google Scholar] [CrossRef]
- World Health Organization. Diet, Nutrition, and the Prevention of Chronic Diseases: Report of a Joint WHO/FAO Expert Consultation; World Health Organization: Geneva, Switzerland, 2003; Volume 916, ISBN 92-4-120916-X. [Google Scholar]
- Kouřimská, L.; Sabolová, M.; Horčička, P.; Rys, S.; Božik, M. Lipid Content, Fatty Acid Profile, and Nutritional Value of New Oat Cultivars. J. Cereal Sci. 2018, 84, 44–48. [Google Scholar] [CrossRef]
- Wani, S.A.; Ganie, N.A.; Kumar, P. Quality Characteristics, Fatty Acid Profile and Glycemic Index of Extrusion Processed Snacks Enriched with the Multicomponent Mixture of Cereals and Legumes. Legume Sci. 2021, 3, e76. [Google Scholar] [CrossRef]
- Ramos Diaz, J.M.; Sundarrajan, L.; Kariluoto, S.; Lampi, A.-M.; Tenitz, S.; Jouppila, K. Effect of Extrusion Cooking on Physical Properties and Chemical Composition of Corn-based Snacks Containing Amaranth and Quinoa: Application of Partial Least Squares Regression. J. Food Process Eng. 2017, 40, e12320. [Google Scholar] [CrossRef]
- SILVA, E.O.O.; Nespolo, C.R.; Sehn, C.P.; Pinheiro, F.C.; Stefani, L.M. Lactic Acid Bacteria with Antimicrobial, Proteolytic and Lipolytic Activities Isolated from Ovine Dairy Products. Food Sci. Technol. 2019, 40, 293–299. [Google Scholar] [CrossRef]
- König, H.; Fröhlich, J. Lactic Acid Bacteria. Biology of Microorganisms on Grapes, in Must and in Wine; Springer: Berlin/Heidelberg, Germany, 2009. [Google Scholar]
- Abbasiliasi, S.; Tan, J.S.; Ibrahim, T.A.T.; Bashokouh, F.; Ramakrishnan, N.R.; Mustafa, S.; Ariff, A.B. Fermentation Factors Influencing the Production of Bacteriocins by Lactic Acid Bacteria: A Review. Rsc Adv. 2017, 7, 29395–29420. [Google Scholar] [CrossRef]
- Szutowska, J. Functional Properties of Lactic Acid Bacteria in Fermented Fruit and Vegetable Juices: A Systematic Literature Review. Eur. Food Res. Technol. 2020, 246, 357–372. [Google Scholar] [CrossRef]
- Arena, M.P.; Capozzi, V.; Russo, P.; Drider, D.; Spano, G.; Fiocco, D. Immunobiosis and Probiosis: Antimicrobial Activity of Lactic Acid Bacteria with a Focus on Their Antiviral and Antifungal Properties. Appl. Microbiol. Biotechnol. 2018, 102, 9949–9958. [Google Scholar] [CrossRef] [PubMed]
- Gao, Z.; Daliri, E.B.-M.; Wang, J.U.N.; Liu, D.; Chen, S.; Ye, X.; Ding, T. Inhibitory Effect of Lactic Acid Bacteria on Foodborne Pathogens: A Review. J. Food Prot. 2019, 82, 441–453. [Google Scholar] [CrossRef] [PubMed]
- Fernandez, B.; Vimont, A.; Desfossés-Foucault, É.; Daga, M.; Arora, G.; Fliss, I. Antifungal Activity of Lactic and Propionic Acid Bacteria and Their Potential as Protective Culture in Cottage Cheese. Food Control 2017, 78, 350–356. [Google Scholar] [CrossRef]
- Gajbhiye, M.H.; Kapadnis, B.P. Antifungal-Activity-Producing Lactic Acid Bacteria as Biocontrol Agents in Plants. Biocontrol Sci. Technol. 2016, 26, 1451–1470. [Google Scholar] [CrossRef]



| Corn By-Product Samples | pH | TTA, °N | Lactic Acid Isomers Content, after 24 h of Fermentation, g/100 g | |||
|---|---|---|---|---|---|---|
| Fermentation Time, h | L (+) | D (−) | ||||
| 0 | 24 | 0 | 24 | |||
| Ccon | 6.05 ± 0.01 a | - | 0.1 ± 0.1 a | - | 0.075 ± 0.008 a | 0.022 ± 0.003 a |
| CconLpl | - | 3.34 ± 0.02 a | - | 4.5 ± 0.2 g | 0.327 ± 0.045 c | 0.600 ± 0.133 f |
| CconLu | - | 3.35 ± 0.05 a | - | 3.8 ± 0.1 e | 0.274 ± 0.028 c | 0.456 ± 0.037 e |
| CconLc | - | 3.30 ± 0.03 a | - | 4.6 ± 0.2 g | 0.310 ± 0.031 c | 0.537 ± 0.12 e |
| CconLpa | - | 3.44 ± 0.02 b | - | 4.0 ± 0.2 f | 0.360 ± 0.043 d | 0.321 ± 0.027 d |
| Cex14 | 6.4 ± 0.02 b | - | 0.2 ± 0.1 a | - | 0.048 ± 0.011 a | 0.017 ± 0.002 a |
| Cex14Lpl | - | 3.67 ± 0.02 e | - | 4.6 ± 0.2 g | 0.261 ± 0.059 c | 0.504 ± 0.086 e |
| Cex14Lu | - | 3.55 ± 0.01 c | - | 3.7 ± 0.1 e | 0.296 ± 0.043 c | 0.409 ± 0.059 e |
| Cex14Lc | - | 3.53 ± 0.01 c | - | 4.5 ± 0.3 g | 0.302 ± 0.029 c | 0.445 ± 0.072 e |
| Cex14Lpa | - | 3.55 ± 0.02 c | - | 3.9 ± 0.3 f | 0.362 ± 0.061 d | 0.337 ± 0.038 d |
| Cex16 | 6.38 ± 0.03 b | - | 0.2 ± 0.1 a | - | 0.124 ± 0.01 a | 0.045 ± 0.007 b |
| Cex16Lpl | - | 3.71 ± 0.01 e | - | 3.4 ± 0.1 e | 0.188 ± 0.033 b | 0.196 ± 0.04 c |
| Cex16Lu | - | 3.69 ± 0.01 e | - | 3.6 ± 0.2 e | 0.284 ± 0.059 c | 0.351 ± 0.065 d |
| Cex16Lc | - | 3.60 ± 0.02 d | - | 2.9 ± 0.1 d | 0.305 ± 0.046 c | 0.435 ± 0.05 e |
| Cex16Lpa | - | 3.71 ± 0.01 e | - | 2.6 ± 0.2 c | 0.333 ± 0.029 c | 0.281 ± 0.06 d |
| Cex18 | 6.43 ± 0.01 b | - | 0.2 ± 0.1 a | - | 0.058 ± 0.01 a | 0.01 ± 0.001 a |
| Cex18Lpl | - | 3.67 ± 0.01 e | - | 5.5 ± 0.1 h | 0.221 ± 0.049 b | 0.251 ± 0.023 d |
| Cex18Lu | - | 3.7 ± 0.02 e | - | 2.3 ± 0.1 b | 0.169 ± 0.035 b | 0.156 ± 0.031 c |
| Cex18Lc | - | 3.68 ± 0.01 e | - | 2.5 ± 0.1 c | 0.241 ± 0.042 b | 0.208 ± 0.027 c |
| Cex18Lpa | - | 4.25 ± 0.01 f | - | 1.8 ± 0.2 a | 0.095 ± 0.014 a | 0.056 ± 0.008 b |
| Corn By- Product Samples | Lactic Acid Bacteria Count | Mould and Yeast Count | Total Bacteria Count | Total Enterobacteria Count |
|---|---|---|---|---|
| log10CFU/g | ||||
| Ccon | 5.41 ± 0.11 b | 4.11 ± 0.05 b | 8.45 ± 0.13 d | 6.06 ± 0.06 d |
| CconLpl | 7.72 ± 0.09 d | 3.72 ± 0.07 a | 8.32 ± 0.09 b | 5.83 ± 0.07 b |
| CconLu | 7.13 ± 0.14 c | 3.80 ± 0.06 a | 8.08 ± 0.08 a | 5.71 ± 0.10 b |
| CconLc | 9.39 ± 0.08 k | 3.72 ± 0.07 a | 8.40 ± 0.09 d | 5.99 ± 0.11 c |
| CconLpa | 9.19 ± 0.15 i | 4.02 ± 0.05 b | 8.24 ± 0.09 b | 6.01 ± 0.07 c |
| Cex14 | 5.11 ± 0.06 a | 4.45 ± 0.08 f | 8.90 ± 0.05 h | 6.72 ± 0.11 h |
| Cex14Lpl | 7.87 ± 0.15 d | 4.21 ± 0.08 c | 8.33 ± 0.08 b | 6.11 ± 0.10 f |
| Cex14Lu | 8.68 ± 0.10 g | 3.99 ± 0.07 b | 8.38 ± 0.10 c | 5.89 ± 0.04 b |
| Cex14Lc | 8.32 ± 0.10 f | 4.12 ± 0.04 b | 8.69 ± 0.05 f | 5.77 ± 0.09 b |
| Cex14Lpa | 8.91 ± 0.09 g | 4.34 ± 0.08 e | 8.78 ± 0.09 g | 6.04 ± 0.05 d |
| Cex16 | 5.52 ± 0.10 b | 5.21 ± 0.06 j | 8.41 ± 0.10 d | 6.24 ± 0.07 g |
| Cex16Lpl | 9.34 ± 0.13 j | 4.92 ± 0.09 h | 9.03 ± 0.11 i | 5.91 ± 0.05 b |
| Cex16Lu | 9.11 ± 0.13 i | 5.16 ± 0.11 j | 8.80 ± 0.09 g | 5.8 ± 0.05 b |
| Cex16Lc | 9.22 ± 0.12 i | 4.84 ± 0.09 h | 8.47 ± 0.16 d | 5.45 ± 0.11 a |
| Cex16Lpa | 8.96 ± 0.12 h | 5.03 ± 0.07 i | 8.21 ± 0.11 b | 6.11 ± 0.12 f |
| Cex18 | 5.52 ± 0.07 b | 4.63 ± 0.09 g | 8.63 ± 0.09 e | 6.07 ± 0.09 e |
| Cex18Lpl | 9.11 ± 0.18 i | 4.56 ± 0.08 g | 9.10 ± 0.10 j | 5.32 ± 0.10 a |
| Cex18Lu | 8.64 ± 0.11 g | 4.22 ± 0.05 d | 8.12 ± 0.05 a | 5.93 ± 0.12 b |
| Cex18Lc | 9.02 ± 0.13 i | 4.45 ± 0.08 f | 8.32 ± 0.07 b | 5.99 ± 0.11 c |
| Cex18Lpa | 8.13 ± 0.11 e | 3.99 ± 0.05 b | 7.94 ± 0.05 a | 6.01 ± 0.11 c |
| Corn By- Product Samples | His | Thr | Val | Met | Trp | Phe | Ile | Leu | Lys |
|---|---|---|---|---|---|---|---|---|---|
| Ccon | 0.080 ± 0.007 d | 0.15 ± 0.02 d | 0.22 ± 0.03 b | 0.060 ± 0.011 b | 0.17 ± 0.02 b | 0.080 ± 0.016 d | 0.36 ± 0.06 d | <LOD | <LOD |
| CconLpl | 0.11 ± 0.02 e | 0.17 ± 0.03 d | 0.22 ± 0.03 b | 0.030 ± 0.005 a | 0.19 ± 0.02 b | 0.090 ± 0.011 e | 0.40 ± 0.04 d | 0.010 ± 0.001 a | <LOD |
| CconLu | 0.110 ± 0.012 e | 0.18 ± 0.03 d | 0.25 ± 0.04 b | 0.050 ± 0.004 a | 0.21 ± 0.04 b | 0.100 ± 0.010 e | 0.41 ± 0.07 d | 0.020 ± 0.003 b | <LOD |
| CconLc | 0.090 ± 0.015 d | 0.17 ± 0.03 d | 0.21 ± 0.02 b | 0.030 ± 0.006 a | 0.18 ± 0.03 b | 0.090 ± 0.012 e | 0.39 ± 0.06 d | 0.010 ± 0.001 a | <LOD |
| CconLpa | 0.110 ± 0.010 e | 0.170 ± 0.027 d | 0.21 ± 0.03 b | 0.030 ± 0.006 a | 0.190 ± 0.019 b | 0.090 ± 0.017 e | 0.43 ± 0.04 d | 0.010 ± 0.001 a | <LOD |
| Cex14 | 0.060 ± 0.005 c | 0.110 ± 0.010 c | 0.15 ± 0.03 a | 0.030 ± 0.006 a | 0.130 ± 0.018 a | 0.060 ± 0.006 d | 0.26 ± 0.03 c | <LOD | <LOD |
| Cex14Lpl | 0.100 ± 0.018 e | 0.190 ± 0.026 e | 0.29 ± 0.03 c | 0.070 ± 0.006 b | 0.20 ± 0.02 b | 0.110 ± 0.016 e | 0.41 ± 0.08 d | 0.020 ± 0.003 b | <LOD |
| Cex14Lu | 0.070 ± 0.008 d | 0.130 ± 0.026 c | 0.180 ± 0.015 a | 0.040 ± 0.007 a | 0.14 ± 0.03 a | 0.060 ± 0.006 d | 0.27 ± 0.05 c | 0.010 ± 0.001 a | <LOD |
| Cex14Lc | 0.070 ± 0.013 d | 0.120 ± 0.018 c | 0.18 ± 0.03 a | 0.040 ± 0.005 a | 0.13 ± 0.02 a | 0.050 ± 0.006 c | 0.25 ± 0.03 c | <LOD | <LOD |
| Cex14Lpa | 0.060 ± 0.005 c | 0.120 ± 0.015 c | 0.180 ± 0.018 a | 0.040 ± 0.008 a | 0.140 ± 0.019 b | 0.060 ± 0.009 d | 0.25 ± 0.03 c | <LOD | <LOD |
| Cex16 | 0.050 ± 0.005 c | 0.100 ± 0.012 c | 0.22 ± 0.02 b | 0.13 ± 0.02 c | 0.120 ± 0.018 a | 0.040 ± 0.005 c | 0.18 ± 0.03 b | <LOD | <LOD |
| Cex16Lpl | 0.050 ± 0.005 c | 0.090 ± 0.013 b | 0.27 ± 0.02 c | 0.18 ± 0.02 d | 0.12 ± 0.02 a | 0.040 ± 0.003 c | 0.18 ± 0.03 b | <LOD | <LOD |
| Cex16Lu | 0.060 ± 0.006 c | 0.130 ± 0.024 d | 0.30 ± 0.04 c | 0.26 ± 0.03 e | 0.16 ± 0.03 b | 0.070 ± 0.008 d | 0.27 ± 0.03 c | <LOD | <LOD |
| Cex16Lc | 0.070 ± 0.007 d | 0.130 ± 0.018 d | 0.39 ± 0.05 d | 0.25 ± 0.02 e | 0.160 ± 0.019 b | 0.070 ± 0.008 d | 0.26 ± 0.04 c | <LOD | <LOD |
| Cex16Lpa | 0.060 ± 0.010 c | 0.130 ± 0.016 d | 0.39 ± 0.05 d | 0.31 ± 0.04 e | 0.170 ± 0.014 b | 0.060 ± 0.012 d | 0.25 ± 0.04 c | <LOD | <LOD |
| Cex18 | 0.020 ± 0.004 a | 0.050 ± 0.008 a | 0.33 ± 0.07 c | 0.36 ± 0.04 f | 0.110 ± 0.013 a | 0.020 ± 0.003 a | 0.110 ± 0.013 a | <LOD | <LOD |
| Cex18Lpl | 0.040 ± 0.004 b | 0.070 ± 0.012 b | 0.43 ± 0.05 d | 0.41 ± 0.06 f | 0.120 ± 0.017 a | 0.030 ± 0.003 b | 0.15 ± 0.02 b | <LOD | <LOD |
| Cex18Lu | <LOD | 0.050 ± 0.008 a | 0.38 ± 0.07 d | 0.40 ± 0.06 f | 0.100 ± 0.011 a | 0.020 ± 0.004 a | 0.100 ± 0.018 a | <LOD | <LOD |
| Cex18Lc | 0.020 ± 0.002 a | 0.050 ± 0.007 a | 0.39 ± 0.04 d | 0.46 ± 0.05 g | 0.100 ± 0.018 a | 0.020 ± 0.003 a | 0.100 ± 0.015 a | <LOD | <LOD |
| Cex18Lpa | 0.030 ± 0.006 a | 0.050 ± 0.004 a | 0.40 ± 0.05 d | 0.49 ± 0.04 g | 0.11 ± 0.02 a | 0.020 ± 0.003 a | 0.100 ± 0.014 a | <LOD | <LOD |
| Corn By- Product Samples | Asp | Glu | Ser | Gly | Arg | Ala | Tyr | Cys | Pro |
|---|---|---|---|---|---|---|---|---|---|
| Ccon | 0.22 ± 0.04 b | 0.69 ± 0.14 d | 0.15 ± 0.013 d | 0.09 ± 0.011 d | <LOD | 0.24 ± 0.03 d | 0.12 ± 0.019 e | 0.31 ± 0.06 a | 0.28 ± 0.02 c |
| CconLpl | 0.26 ± 0.05 c | 0.74 ± 0.06 d | 0.18 ± 0.03 d | 0.13 ± 0.019 e | 0.05 ± 0.006 d | 0.24 ± 0.04 d | 0.13 ± 0.018 e | 0.24 ± 0.03 a | 0.19 ± 0.02 a |
| CconLu | 0.27 ± 0.04 c | 0.76 ± 0.15 d | 0.24 ± 0.03 e | 0.14 ± 0.02 e | 0.05 ± 0.005 d | 0.26 ± 0.02d | 0.14 ± 0.02 e | 0.33 ± 0.03 a | 0.32 ± 0.04 c |
| CconLc | 0.26 ± 0.04 c | 0.75 ± 0.07 d | 0.17 ± 0.018 d | 0.12 ± 0.010 e | 0.05 ± 0.007 d | 0.24 ± 0.05 d | 0.13 ± 0.017 e | 0.23 ± 0.04 a | 0.31 ± 0.05 c |
| CconLpa | 0.25 ± 0.03 c | 0.79 ± 0.12 d | 0.18 ± 0.03 d | 0.11 ± 0.019 d | 0.03 ± 0.004 c | 0.25 ± 0.02 d | 0.14 ± 0.015 e | 0.22 ± 0.04 a | 0.23 ± 0.03 b |
| Cex14 | 0.18 ± 0.03 b | 0.52 ± 0.10 c | 0.12 ± 0.013 c | 0.08 ± 0.012 d | <LOD | 0.17 ± 0.02 b | 0.09 ± 0.008 d | 0.20 ± 0.03 a | 0.29 ± 0.05 c |
| Cex14Lpl | 0.30 ± 0.03 d | 0.83 ± 0.14 d | 0.22 ± 0.04 e | 0.16 ± 0.03 f | 0.08 ± 0.014 e | 0.28 ± 0.03 d | 0.14 ± 0.03 e | 0.37 ± 0.05 a | 0.31 ± 0.03 c |
| Cex14Lu | 0.20 ± 0.02 b | 0.55 ± 0.10 c | 0.14 ± 0.03 c | 0.11 ± 0.02 d | 0.02 ± 0.002 b | 0.19 ± 0.03 c | 0.09 ± 0.017 d | 0.23 ± 0.04 a | 0.22 ± 0.03 b |
| Cex14Lc | 0.19 ± 0.04 b | 0.53 ± 0.10 c | 0.11 ± 0.011 c | 0.09 ± 0.009 d | <LOD | 0.18 ± 0.022 c | 0.09 ± 0.016 d | 0.27 ± 0.03 a | 0.25 ± 0.04 c |
| Cex14Lpa | 0.19 ± 0.02 b | 0.52 ± 0.06 c | 0.12 ± 0.019 c | 0.10 ± 0.016 d | <LOD | 0.18 ± 0.016 c | 0.08 ± 0.012 c | 0.26 ± 0.04 a | 0.28 ± 0.06 c |
| Cex16 | 0.15 ± 0.02 a | 0.41 ± 0.06 b | 0.12 ± 0.013 c | 0.07 ± 0.012 c | <LOD | 0.14 ± 0.014 b | 0.07 ± 0.011 c | 0.53 ± 0.05 b | 0.21 ± 0.02 b |
| Cex16Lpl | 0.14 ± 0.02 a | 0.42 ± 0.06 b | 0.08 ± 0.014 b | 0.06 ± 0.007 c | <LOD | 0.14 ± 0.018 b | 0.06 ± 0.010 c | 0.69 ± 0.07 c | 0.23 ± 0.03 b |
| Cex16Lu | 0.20 ± 0.04 b | 0.59 ± 0.05 c | 0.13 ± 0.019 c | 0.09 ± 0.013 d | <LOD | 0.2 ± 0.04 c | 0.10 ± 0.009 d | 0.82 ± 0.14 c | 0.24 ± 0.04 b |
| Cex16Lc | 0.21 ± 0.03 b | 0.60 ± 0.06 c | 0.13 ± 0.03 c | 0.10 ± 0.018 d | 0.01 ± 0.002 a | 0.21 ± 0.03 c | 0.09 ± 0.009 d | 0.96 ± 0.18 d | 0.30 ± 0.04 c |
| Cex16Lpa | 0.20 ± 0.03 b | 0.59 ± 0.08 c | 0.13 ± 0.02 c | 0.09 ± 0.008 d | <LOD | 0.20 ± 0.02 c | 0.10 ± 0.012 d | 1.05 ± 0.14 d | 0.33 ± 0.06 c |
| Cex18 | 0.09 ± 0.011 a | 0.26 ± 0.05 a | 0.04 ± 0.005 a | 0.02 ± 0.003 a | <LOD | 0.09 ± 0.014 a | 0.04 ± 0.007 b | 1.25 ± 0.13 d | 0.19 ± 0.02 a |
| Cex18Lpl | 0.13 ± 0.016 a | 0.35 ± 0.03 b | 0.06 ± 0.008 a | 0.05 ± 0.010 c | <LOD | 0.13 ± 0.02 b | 0.05 ± 0.006 b | 1.40 ± 0.13 e | 0.20 ± 0.04 a |
| Cex18Lu | 0.09 ± 0.015 a | 0.25 ± 0.05 a | 0.04 ± 0.004 a | 0.03 ± 0.003 b | <LOD | 0.09 ± 0.015 a | 0.03 ± 0.002 a | 1.47 ± 0.12 e | 0.18 ± 0.03 a |
| Cex18Lc | 0.09 ± 0.008 a | 0.24 ± 0.04 a | 0.04 ± 0.007 a | 0.03 ± 0.005 b | <LOD | 0.09 ± 0.008 a | 0.03 ± 0.006 a | 1.62 ± 0.17 e | 0.16 ± 0.03 a |
| Cex18Lpa | 0.09 ± 0.015 a | 0.26 ± 0.03 a | 0.03 ± 0.005 a | 0.04 ± 0.005 b | <LOD | 0.09 ± 0.009 a | 0.03 ± 0.006 a | 1.69 ± 0.25 e | 0.17 ± 0.017 a |
| Corn By- Product Samples | Saturated | Mono- Unsaturated | Poly- Unsaturated | Trans | Omega 3 | Omega 6 | Omega 9 |
|---|---|---|---|---|---|---|---|
| Ccon | 13.4 ± 1.7 a | 33.4 ± 6.5 a | 53.2 ± 9.9 b | nd | 1.39 ± 0.14 a | 51.8 ± 9.7 a | 33.2 ± 7.0 a |
| CconLpl | 12.9 ± 1.5 a | 33.4 ± 4.6 a | 53.7 ± 5.3 b | 0.010 ± 0.001 a | 1.15 ± 0.26 a | 52.6 ± 5.3 a | 33.3 ± 4.2 a |
| CconLu | 13.0 ± 1.9 a | 33.5 ± 4.5 a | 53.4 ± 11.5 b | 0.010 ± 0.002 a | 1.23 ± 0.10 a | 52.2 ± 7.4 a | 33.4 ± 5.4 a |
| CconLc | 13.0 ± 2.1 a | 33.3 ± 3.9 a | 53.7 ± 9.2 b | 0.010 ± 0.001 a | 1.22 ± 0.12 a | 52.5 ± 5.7 a | 33.2 ± 6.1 a |
| CconLpa | 12.8 ± 1.2 a | 33.5 ± 4.0 a | 53.6 ± 8.5 b | 0.010 ± 0.001 a | 1.09 ± 0.21 a | 52.5 ± 11.7 a | 33.4 ± 6.5 a |
| Cex14 | 14.2 ± 2.9 a | 33.2 ± 5.0 a | 52.6 ± 4.7 b | nd | 1.67 ± 0.30 b | 50.9 ± 7.6 a | 33.0 ± 2.7 a |
| Cex14Lpl | 12.9 ± 2.6 a | 33.4 ± 4.7 a | 53.7 ± 6.1 b | nd | 1.85 ± 0.31 b | 51.9 ± 7.1 a | 33.2 ± 3.7 a |
| Cex14Lu | 13.3 ± 2.1 a | 33.7 ± 3.0 a | 53.1 ± 6.5 b | nd | 1.34 ± 0.23 a | 51.8 ± 10.7 a | 33.4 ± 3.8 a |
| Cex14Lc | 17.1 ± 2.8 b | 33.1 ± 7.0 a | 49.9 ± 7.3 b | nd | 1.95 ± 0.38 b | 47.9 ± 7.9 a | 32.8 ± 6.6 a |
| Cex14Lpa | 15.0 ± 2.9 a | 33.7 ± 2.8 a | 51.3 ± 9.0 b | nd | 1.68 ± 0.29 b | 49.6 ± 4.0 a | 33.6 ± 3.1 a |
| Cex16 | 14.0 ± 2.7 a | 33.3 ± 7.0 a | 52.7 ± 11.4 b | nd | 1.73 ± 0.32 b | 51.0 ± 7.6 a | 33.2 ± 5.5 a |
| Cex16Lpl | 16.0 ± 3.0 a | 33.1 ± 5.4 a | 50.9 ± 4.5 b | nd | 2.12 ± 0.40 b | 48.7 ± 6.1 a | 33.0 ± 6.3 a |
| Cex16Lu | 16.1 ± 2.7 a | 33.9 ± 4.6 a | 50.0 ± 4.2 a | nd | 1.98 ± 0.27 b | 48.0 ± 8.4 a | 33.7 ± 2.8 a |
| Cex16Lc | 14.1 ± 1.8 a | 33.6 ± 2.8 a | 52.3 ± 4.5 b | nd | 1.77 ± 0.17 b | 50.5 ± 11.5 a | 33.4 ± 4.7 a |
| Cex16Lpa | 14.8 ± 1.6 a | 34.4 ± 2.8 a | 50.8 ± 8.0 b | nd | 1.7 ± 0.37 b | 49.1 ± 5.0 a | 34.3 ± 4.1 a |
| Cex18 | 14.3 ± 2.9 a | 33.5 ± 5.4 a | 52.3 ± 9.3 b | nd | 1.84 ± 0.21 b | 50.5 ± 6.7 a | 33.2 ± 4.4 a |
| Cex18Lpl | 20.7 ± 3.6 b | 32.9 ± 2.7 a | 46.4 ± 7.6 b | 0.080 ± 0.018 b | 1.99 ± 0.43 b | 44.4 ± 9.0 a | 32.5 ± 5.1 a |
| Cex18Lu | 15. 9 ± 3.4 a | 34.1 ± 4.0 a | 50.0 ± 11.4 b | nd | 3.24 ± 0.46 d | 46.8 ± 7.6 a | 33.9 ± 3.1 a |
| Cex18Lc | 20.3 ± 4.6 b | 34.8 ± 3.1 a | 44.9 ± 4.7 b | nd | 3.61 ± 0.48 d | 41.3 ± 8.4 a | 34.3 ± 4.1 a |
| Cex18Lpa | 15.0 ± 1.4 a | 33.1 ± 7.3 a | 51.9 ± 4.7 b | nd | 2.54 ± 0.20 c | 49.3 ± 8.7 a | 33.0 ± 5.1 a |
| Corn By- Product Samples | Pathogens | |||
|---|---|---|---|---|
| Staphylococcus aureus LT 102 | Aeromonas veronii LT 105 | Acinetobacter johnsonii LT 110 | ||
| Diameter of Inhibition Zones, mm | ||||
| Ccon | nd | nd | nd | |
| CconLpl | 11.0 ± 0.2 c | 12.3 ± 0.3 c | 15.3 ± 0.1 g | |
| CconLu | 9.2 ± 0.1 a | 9.6 ± 0.2 b | 11.2 ± 0.4 c | |
| CconLc | 9.1 ± 0.1 a | nd | 9.4 ± 0.3 b | |
| CconLpa | 10.3 ± 0.4 b | 9.0 ± 0.4 a | 12.7 ± 0.2 d | |
| Cex14 | nd | nd | nd | |
| Cex14Lpl | nd | nd | 11.8 ± 0.5 c | |
| Cex14Lu | nd | nd | 12.3 ± 0.3 d | |
| Cex14Lc | nd | nd | 12.5 ± 0.6 d | |
| Cex14Lpa | nd | nd | 12.2 ± 0.2 d | |
| Cex16 | nd | nd | nd | |
| Cex16Lpl | nd | nd | 14.3 ± 0.3 f | |
| Cex16Lu | nd | nd | 14.4 ± 0.2 f | |
| Cex16Lc | nd | nd | 7.20 ± 0.10 a | |
| Cex16Lpa | nd | nd | 13.6 ± 0.3 e | |
| Cex18 | nd | nd | nd | |
| Cex18Lpl | nd | nd | nd | |
| Cex18Lu | nd | nd | 12.2 ± 0.3 d | |
| Cex18Lc | nd | nd | 15.6 ± 0.2 g | |
| Cex18Lpa | nd | nd | nd | |
![]() | ![]() | ![]() | ![]() | |
| Against Staphylococcus aureus | Against Aeromonas veronii | Against Acinetobacter johnsonii | ||
| Fungi | Corn By-Product Samples | |||||||||||||||||||
|---|---|---|---|---|---|---|---|---|---|---|---|---|---|---|---|---|---|---|---|---|
| Ccon | CconLpl | CconLu | CconLc | CconLpa | Cex14 | Cex14Lpl | Cex14Lu | Cex14Lc | Cex14Lpa | Cex16 | Cex16Lpl | Cex16Lu | Cex16Lc | Cex16Lpa | Cex18 | Cex18Lpl | Cex18Lu | Cex18Lc | Cex18Lpa | |
| Aspergillus fumigatus | - | - | - | - | - | - | + | - | - | - | - | - | - | - | - | - | - | - | - | - |
| Rhizopus | - | - | - | - | - | - | + | + | + | + | - | - | - | - | - | - | - | + | + | + |
Publisher’s Note: MDPI stays neutral with regard to jurisdictional claims in published maps and institutional affiliations. |
© 2022 by the authors. Licensee MDPI, Basel, Switzerland. This article is an open access article distributed under the terms and conditions of the Creative Commons Attribution (CC BY) license (https://creativecommons.org/licenses/by/4.0/).
Share and Cite
Bartkiene, E.; Starkute, V.; Zokaityte, E.; Klupsaite, D.; Bartkevics, V.; Zokaityte, G.; Cernauskas, D.; Ruzauskas, M.; Ruibys, R.; Viksna, A. Combined Thermomechanical–Biological Treatment for Corn By-Product Valorization into Added-Value Food (Feed) Material. Plants 2022, 11, 3080. https://doi.org/10.3390/plants11223080
Bartkiene E, Starkute V, Zokaityte E, Klupsaite D, Bartkevics V, Zokaityte G, Cernauskas D, Ruzauskas M, Ruibys R, Viksna A. Combined Thermomechanical–Biological Treatment for Corn By-Product Valorization into Added-Value Food (Feed) Material. Plants. 2022; 11(22):3080. https://doi.org/10.3390/plants11223080
Chicago/Turabian StyleBartkiene, Elena, Vytaute Starkute, Egle Zokaityte, Dovile Klupsaite, Vadims Bartkevics, Gintare Zokaityte, Darius Cernauskas, Modestas Ruzauskas, Romas Ruibys, and Arturs Viksna. 2022. "Combined Thermomechanical–Biological Treatment for Corn By-Product Valorization into Added-Value Food (Feed) Material" Plants 11, no. 22: 3080. https://doi.org/10.3390/plants11223080
APA StyleBartkiene, E., Starkute, V., Zokaityte, E., Klupsaite, D., Bartkevics, V., Zokaityte, G., Cernauskas, D., Ruzauskas, M., Ruibys, R., & Viksna, A. (2022). Combined Thermomechanical–Biological Treatment for Corn By-Product Valorization into Added-Value Food (Feed) Material. Plants, 11(22), 3080. https://doi.org/10.3390/plants11223080